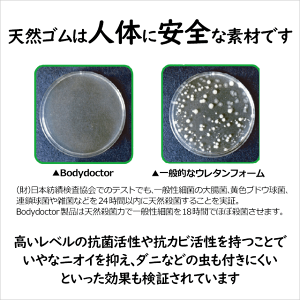

【シーツのおまけ付】ボディドクター Futon5(フートン5)
数量
52,800円(税込)
当店ポイント528pt進呈
サイズ
製造元bodydoctor(ボディドクター)
ボディドクターFUTON5(フートン5)の解説
ボディドクターは、100%天然純粋のラテックスフォームを使用したマットレスです。柔らかすぎず、硬すぎず、快適な弾力性があり、体圧分散の効果で身体に負担がかからず、らくに寝られるのが特徴です。厚みは8.5cmですが、高密度のラテックスの特質から床あたりするようなことはなし。浮遊したような感じで仰向けでも横向きでも、体重のある方でも華奢な方でも快適に寝られます。
さらに 特筆すべきは、その耐久性。へたりが少なく、10~15年は安心して使えます(5年間のはメーカー保証付)。
また、天然の殺菌力により、細菌が繁殖する心配が少ないことから、医療や介護の現場でも使われています。ダニもよせつけないから、ダニでお悩みの方にも安心してお使いいただけます。
ボディドクターFUTON5(フートン5)の詳細
| サイズ | シングル:97x195cm 厚さ8.5cm、約10kg
セミダブル:120x195cm 厚さ8.5cm、約12kg |
| 中材 | 100%天然ラテックスフォーム |
| 側生地 | 綿52%、ポリエステル48% |
| 大分類 | 寝具 > 敷布団 |
| こんな方に おすすめ |
・熟睡ができない方 ・腰痛、肩こりでお悩みの方 ・ハウスダストアレルギーの方 ・ストレスの解消や疲労回復 ・ベッドマットレスの寝心地を改善したい方 ・すのこベッドのマットレスをお探しの方 |
| 推奨 | 和室、フローリング、すのこ、ベッド |
| 製造 | 原産国:中身/マレーシア 側地加工/日本 |
| その他 | ・5年保証 ・送料無料 |
【シーツのおまけ付】ボディドクター Futon5(フートン5)
52,800円(税込)